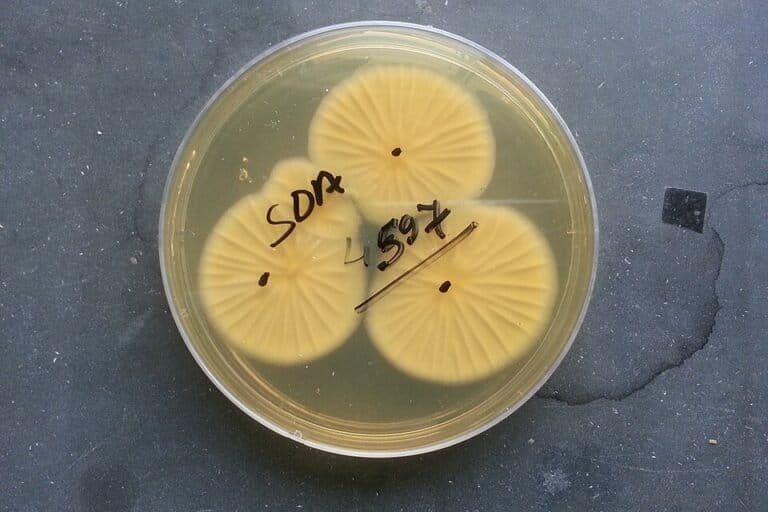
Jamur Invasif yang Menginfeksi Organ Tubuh Menyebar Cepat Seiring Suhu Bumi yang Memanas

The invisible world of fungal spores, once considered a secondary concern in the realm of infectious diseases, is rapidly transforming into a primary threat to global public health, food security, and ecological stability. Every day, the average human inhales thousands of fungal spores without consequence, as robust immune systems typically neutralize these microscopic invaders before they can take root. However, a growing body of evidence suggests that the boundary between benign environmental organisms and lethal pathogens is dissolving. Driven by the dual pressures of climate change and intensive agricultural practices, a small but dangerous group of fungi is evolving, spreading across borders, and developing resistance to the very medications designed to stop them.
The transition of fungi from essential decomposers in the natural world to aggressive invaders of human tissue and agricultural stores marks a significant shift in the global biological landscape. Historically, fungi have played a vital role in Earth’s nutrient cycle, breaking down organic matter and returning essential elements to the soil. Yet, as environmental conditions shift, species such as those in the Aspergillus genus are demonstrating an alarming capacity for adaptation. These microorganisms are no longer confined to the forest floor; they are now appearing with increasing frequency in hospital wards, industrial grain silos, and even within the fragile ecosystems of coral reefs and insect colonies.
The Rise of Aspergillus: A Multi-Front Threat
Recent research led by Dr. Norman van Rhijn and a team of specialists at the University of Manchester has cast a spotlight on the accelerating spread of three specific species: Aspergillus flavus, Aspergillus fumigatus, and Aspergillus niger. These pathogens are at the center of a burgeoning crisis that links environmental health directly to human survival. Using advanced MaxENT modeling to map current and future distributions, the research team has projected how these fungi will behave under various climate scenarios through the end of the 21st century.
The findings are stark. In scenarios where global reliance on fossil fuels remains high and carbon emissions continue to climb, the habitat for these dangerous pathogens will expand significantly. As temperatures rise, regions that were once too cold for these species are becoming hospitable, effectively turning temperate zones into new breeding grounds for infection. Conversely, in some tropical regions, temperatures may eventually exceed the upper limits for certain fungal strains, leading to complex and unpredictable shifts in local ecosystems that could further destabilize food production.
Aspergillus fumigatus is perhaps the most notorious of the trio, recognized as a leading cause of invasive aspergillosis—a severe respiratory infection with a high mortality rate among immunocompromised patients. Aspergillus flavus, meanwhile, is a double threat; it infects human lungs and produces aflatoxins, potent carcinogens that contaminate staple crops like maize and nuts, leading to massive economic losses and long-term health risks for populations reliant on these foods. Aspergillus niger, though often used in industrial fermentation, has emerged as an opportunistic pathogen capable of causing serious ear and lung infections.

The Evolutionary Pressure of Industrial Agriculture
One of the most critical factors driving the current fungal crisis is the overlap between agricultural chemicals and medical treatments. For decades, farmers have relied on azole-based fungicides to protect crops from blights and molds. These same azole compounds are the primary class of drugs used by doctors to treat fungal infections in humans. This dual-use strategy has inadvertently created a massive, outdoor laboratory for natural selection.
When fungi in the soil or on crops are exposed to sub-lethal doses of agricultural fungicides, they develop survival mechanisms. Those that survive carry mutations that make them resistant to the chemical. When these resistant spores are carried by the wind into cities and eventually inhaled by vulnerable individuals—such as those recovering from severe viral infections like COVID-19 or influenza—medical professionals find themselves powerless. The standard "first-line" treatments fail because the fungus has already "learned" how to defeat the drug while it was still in the field.
This phenomenon mirrors the well-documented crisis of antibiotic resistance in bacteria but presents a more complex challenge. Fungi are eukaryotic organisms, meaning their cellular structure is more similar to human cells than bacteria are. This similarity makes it notoriously difficult to develop new antifungal drugs that kill the pathogen without causing toxic side effects in the patient, such as liver or kidney damage.
Climate Change as a Biological Catalyst
The warming of the planet acts as a catalyst for fungal evolution in two primary ways. First, it expands the geographic range of pathogens. As winters become milder and summers longer, fungi that were previously restricted to the tropics are moving northward and southward into the world’s most productive agricultural belts and most densely populated cities.
Second, climate change is training fungi to survive at higher temperatures. Historically, many fungi could not infect humans because the human body’s internal temperature of 37°C (98.6°F) acted as a natural thermal barrier. Most environmental fungi preferred cooler, damp environments. However, as the ambient environment warms, fungi are undergoing "thermal adaptation." Those that can survive heat waves in the wild are more likely to survive the heat of a human body, effectively jumping the species barrier and becoming more potent human pathogens.
The University of Manchester study highlights that if current climate trends continue, the "risk zones" for Aspergillus species will cover nearly every inhabited continent by 2100. This shift is not a distant future concern; clinicians are already reporting an uptick in cases of "super-fungus" infections in regions where they were previously rare.

Economic Implications and Food Insecurity
Beyond the direct threat to human life, the spread of Aspergillus poses a catastrophic risk to the global economy and food supply. The agricultural sector loses billions of dollars annually to fungal contamination. When a grain silo is infected with Aspergillus flavus, the resulting aflatoxin contamination can render the entire harvest unfit for human or animal consumption.
In developing nations, where food storage infrastructure is often less robust, the problem is magnified. High humidity and rising temperatures accelerate fungal growth in storage, leading to a cycle of poverty and malnutrition. Farmers are often faced with an impossible choice: discard their only source of income and food, or consume contaminated grain that leads to chronic illness and liver cancer.
Furthermore, the need for more aggressive fungicide applications to combat these resilient strains creates a feedback loop. Increased chemical use leads to higher production costs for farmers and further drives the evolution of drug-resistant strains, complicating both the economic and public health outlook.
The Need for a "One Health" Response
The burgeoning fungal threat has prompted calls from the scientific community for a "One Health" approach—a strategy that recognizes the interconnectedness of human, animal, and environmental health. In 2022, the World Health Organization (WHO) released its first-ever list of fungal "priority pathogens," placing Aspergillus fumigatus in the "critical priority" group. This move was intended to galvanize research and development, which has historically lagged far behind the study of viruses and bacteria.
Medical experts and environmental scientists argue that the current regulatory framework for fungicides must be overhauled. There is a growing consensus that the use of certain classes of chemicals in agriculture should be restricted if those same chemicals are essential for human medicine. However, such policies face significant pushback from the global agricultural lobby, which fears a drop in crop yields and a subsequent rise in food prices.
In addition to regulatory changes, there is an urgent need for improved global surveillance. Currently, many countries lack the diagnostic tools to identify specific fungal strains or test for drug resistance. Without accurate data, it is impossible to track the spread of these pathogens in real-time or to provide patients with the correct treatments before it is too late.
Conclusion and Future Outlook
The trajectory of the Aspergillus genus serves as a sobering reminder of the unintended consequences of human activity. By altering the climate and saturating the environment with antifungal chemicals, humanity has fundamentally changed the evolutionary path of some of the world’s most resilient organisms.
The mortality rate for invasive fungal infections remains alarmingly high, often exceeding 50% for resistant strains. As the number of vulnerable people grows—due to aging populations, the rise of autoimmune diseases, and the aftermath of global respiratory pandemics—the intersection of a warming world and a more aggressive fungal kingdom creates a "perfect storm" for public health.
The research conducted by Dr. van Rhijn and his colleagues provides a roadmap for the challenges ahead. It underscores that the fight against infectious diseases cannot be won in hospitals alone; it must also be fought in the fields, in the atmosphere, and through international policy. As the century progresses, the ability of global society to adapt to this shifting biological reality will determine the resilience of both our healthcare systems and our food supplies. The spores are already here; the question remains whether our global response can evolve as quickly as they do.






